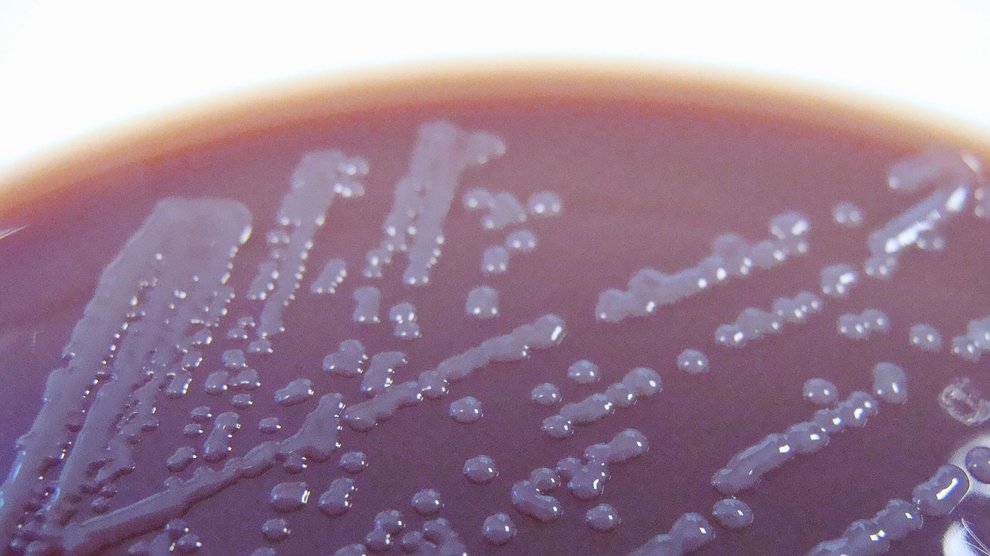
Rothia mucilaginosa culture

Value your independence? You may want to thank your city’s sewage system. Enjoy reading the musings of Voltaire, the 18
th century Enlightenment thinker? Perhaps France’s fair weather should be considered a collaborator. According to evolutionary biologists Randy Thornhill and Corey Fincher, culture’s triumphs—along with its shortfalls—may be the result of diseases.
Thornhill and Fincher began investigating how humans respond to disease a little over a decade ago. The pair quickly zeroed in on a how a region’s pathogen diversity, or the variation in types of disease causing agents such as viruses, bacteria, and parasites, influences its culture.
Ethan Watters, reporting for Pacific Standard:
Our moment-to-moment psychological reactions to the threat of illness, they suggest, have a huge cumulative effect on culture. Not only that—and here’s where Thornhill’s theory really starts to fire the imagination—these deep interactions between local pathogens and human social evolution may explain many of the basic differences we observe between cultures. How does your culture behave toward strangers? What kind of government do you live under? Who are your sexual partners? What values do you share? All of these questions may mask a more fundamental one: What germs are you warding off?
The gist of Thornhill and Fincher’s findings is that regions with fewer diseases have developed into more independent, liberal societies—they didn’t have to worry about foreigners importing illness, for example—while areas that are rife with pathogens are more collectivist and conservative—a behavioral immune response that Thornhill and Fincher say helps ward off disease.
Their theory, needless to say, has sparked a controversy among social scientists, some of whom claim that Thornhill and Fincher are implying causation where there is merely correlation. Others cite numerous counter examples that appear to undermine the argument. But there are plenty of instances where the data backs the idea. Be sure to add Watters’s article to your list—it’s a compelling read that dives into the nuance of a thought-provoking theory.


